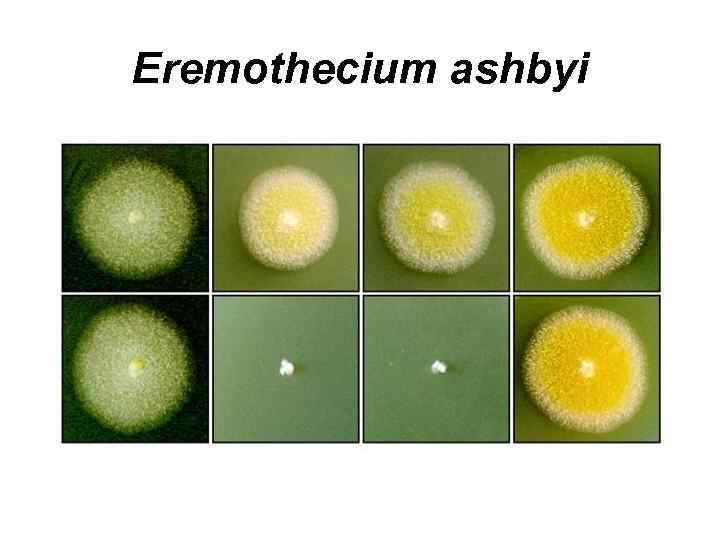
Eremothecium ashbyi

МИКОЛОГИЯ
МИКОЛОГИЯ
 Теофраст (IV век до н. э. )
Теофраст (IV век до н. э. )
 Х. Персоон
Х. Персоон
 Э. Фриз
Э. Фриз
 Антон де Бари
Антон де Бари
 М. С. Воронин
М. С. Воронин
 А. А. Ячевский
А. А. Ячевский
 Л. И. Курсанов
Л. И. Курсанов
 А. С. Бондарцев
А. С. Бондарцев
 М. Н. Мэдиш
М. Н. Мэдиш
 Н. А. Дорожкин
Н. А. Дорожкин
 В. Ф. Купревич
В. Ф. Купревич
 Г. А. Сержанина
Г. А. Сержанина
 Э. П. Комарова
Э. П. Комарова
 Слизевики
Слизевики
 Stemonitis sp.
Stemonitis sp.
 Stemonitis sp.
Stemonitis sp.
 Trichia sp.
Trichia sp.
 Arcyria sp.
Arcyria sp.
 Leocarpus sp.
Leocarpus sp.
 Physarum sp.
Physarum sp.
 Lycogala epidendrum
Lycogala epidendrum
 Fuligo septica
Fuligo septica
 Tubifera sp.
Tubifera sp.
 Кила крестоцветных (возбудитель – Plasmodiophora brassicae)
Кила крестоцветных (возбудитель – Plasmodiophora brassicae)
 Порошистая парша картофеля Возбудитель – Spongospora subterranea
Порошистая парша картофеля Возбудитель – Spongospora subterranea
 ГРИБЫ
ГРИБЫ
 Ризоморфы
Ризоморфы
 Столоны
Столоны
 Склероции
Склероции
 Строма
Строма
 Oomycota
Oomycota
 Saprolegnia sp.
Saprolegnia sp.
 Achlya sp. Dictyuchus sp.
Achlya sp. Dictyuchus sp.
 Aplanes sp.
Aplanes sp.
 Phytophthora infestans
Phytophthora infestans
 Plasmopara viticola
Plasmopara viticola
 Albugo candida
Albugo candida
 Chytridiomycota
Chytridiomycota
 Synchytrium endobioticum
Synchytrium endobioticum
 Olpidium brassicae
Olpidium brassicae
 Polyphagus euglenae
Polyphagus euglenae
 Rhizophydium sp.
Rhizophydium sp.
 Класс Archiascomycetes Порядок Taphrinales
Класс Archiascomycetes Порядок Taphrinales
 Taphrina
Taphrina
 Taphrina pruni
Taphrina pruni
 Класс Hemiascomycetes Порядок Endomycetales Eremascus
Класс Hemiascomycetes Порядок Endomycetales Eremascus
Eremothecium ashbyi
Eremothecium ashbyi
 Порядок Saccharomycetales Saccharomyces cerevisiae
Порядок Saccharomycetales Saccharomyces cerevisiae
 Класс Ascomycetes (Euascomycetes) Группа порядков Плектомицеты Порядок Eurotiales
Класс Ascomycetes (Euascomycetes) Группа порядков Плектомицеты Порядок Eurotiales
 Eurotium sp. (телеоморфа) Aspergillus sp. (анаморфа)
Eurotium sp. (телеоморфа) Aspergillus sp. (анаморфа)
 Talaromyces sp. (телеоморфа) Penicillium sp. (анаморфа)
Talaromyces sp. (телеоморфа) Penicillium sp. (анаморфа)
 Arthroderma sp. (телеоморфа) Microsporum sp. (анаморфа)
Arthroderma sp. (телеоморфа) Microsporum sp. (анаморфа)
 Nanizzia sp. (телеоморфа) Trichophyton sp. (анаморфа)
Nanizzia sp. (телеоморфа) Trichophyton sp. (анаморфа)
 Группа порядков Пиреномицеты Порядок Erysiphales
Группа порядков Пиреномицеты Порядок Erysiphales

 Порядок Sordariales Sordaria sp.
Порядок Sordariales Sordaria sp.
 Neurospora crassa
Neurospora crassa
 Порядок Xylariales Hypoxylon sp.
Порядок Xylariales Hypoxylon sp.
 Xylaria sp.
Xylaria sp.
 Порядок Hypocreales Nectria galligena (телеоморфа) Сylindrocarpon mali (анаморфа)
Порядок Hypocreales Nectria galligena (телеоморфа) Сylindrocarpon mali (анаморфа)
 Gibberella zeae (телеоморфа) Fusarium graminearum (анаморфа)
Gibberella zeae (телеоморфа) Fusarium graminearum (анаморфа)
 Calonectria graminicola (телеоморфа) Fusarium nivale (анаморфа)
Calonectria graminicola (телеоморфа) Fusarium nivale (анаморфа)
 Hypocrea sp. (телеоморфа) Trichoderma sp. (анаморфа)
Hypocrea sp. (телеоморфа) Trichoderma sp. (анаморфа)
 Порядок Clavicipitales Claviceps purpurea (телеоморфа) Sphacelia segetum (анаморфа)
Порядок Clavicipitales Claviceps purpurea (телеоморфа) Sphacelia segetum (анаморфа)
 Epichloë typhina
Epichloë typhina
 Сordyceps sp.
Сordyceps sp.
 Порядок Laboulbeniales Laboulbenia sp.
Порядок Laboulbeniales Laboulbenia sp.
 Группа порядков Дискомицеты
Группа порядков Дискомицеты
 Порядок Helotiales (Leotiales) Monilinia fructigena (телеоморфа) Monilia fructigena (анаморфа)
Порядок Helotiales (Leotiales) Monilinia fructigena (телеоморфа) Monilia fructigena (анаморфа)
 Bortyotinia fuckeliana (телеоморфа) Botrytis cinerea (анаморфа)
Bortyotinia fuckeliana (телеоморфа) Botrytis cinerea (анаморфа)
 Sclerotinia sclerotiorum
Sclerotinia sclerotiorum
 Bisporella citrina
Bisporella citrina
 Spathularia sp.
Spathularia sp.
 Cudonia sp.
Cudonia sp.
 Порядок Rhytismatales Rhytisma acerinum (телеоморфа) Melasmia acerina (анаморфа)
Порядок Rhytismatales Rhytisma acerinum (телеоморфа) Melasmia acerina (анаморфа)
 Lophodermium seditiosum
Lophodermium seditiosum
 Порядок Pezizales Peziza sp.
Порядок Pezizales Peziza sp.
 Aleuria sp.
Aleuria sp.
 Sarcoscypha sp.
Sarcoscypha sp.
 Morchella sp.
Morchella sp.
 Gyromitra sp.
Gyromitra sp.
 Порядок Tuberales Tuber melanosporum
Порядок Tuberales Tuber melanosporum
 Класс Loculoascomycetes Порядок Myriangiales Elsinoë veneta (телеоморфа) Gloeosporium venetum (анаморфа)
Класс Loculoascomycetes Порядок Myriangiales Elsinoë veneta (телеоморфа) Gloeosporium venetum (анаморфа)
 Порядок Dothideales Mycosphaerella fragariae (телеоморфа) Ramularia tulasnei (анаморфа)
Порядок Dothideales Mycosphaerella fragariae (телеоморфа) Ramularia tulasnei (анаморфа)
 Порядок Pleosporales Venturia inaequalis (телеоморфа) Fusicladium dendriticum (анаморфа)
Порядок Pleosporales Venturia inaequalis (телеоморфа) Fusicladium dendriticum (анаморфа)
 Отдел Basidiomycota
Отдел Basidiomycota
 Гимнокарпные плодовые тела
Гимнокарпные плодовые тела
 Ангиокарпные плодовые тела
Ангиокарпные плодовые тела
 Гемиангиокарпные плодовые тела
Гемиангиокарпные плодовые тела
 С общим покрывалом Amanitopsis sp.
С общим покрывалом Amanitopsis sp.
 С частным покрывалом Suillus sp.
С частным покрывалом Suillus sp.
 С общим и частным покрывалами Amanita phalloides
С общим и частным покрывалами Amanita phalloides
 Класс Basidiomycetes
Класс Basidiomycetes
 Подкласс Homobasidiomycetidae (Holobasidiomycetidae)
Подкласс Homobasidiomycetidae (Holobasidiomycetidae)
 Группа порядков Гименомицеты
Группа порядков Гименомицеты
 Афиллофороидные гименомицеты
Афиллофороидные гименомицеты
 Порядок Polyporales
Порядок Polyporales
 Sparassis crispa
Sparassis crispa
 Ramaria sp.
Ramaria sp.
 Serpula lacrymans
Serpula lacrymans
 Daedalea quercina
Daedalea quercina
 Fomes fomentarius
Fomes fomentarius
 Phellinus igniarius
Phellinus igniarius
 Fomitopsis pinicola
Fomitopsis pinicola
 Laetiporus sulphureus
Laetiporus sulphureus
 Heterobasidion annosum
Heterobasidion annosum
 Inonotus obliquus
Inonotus obliquus
 Coltricia perennis
Coltricia perennis
 Порядок Cantharellales Cantharellus cibarius
Порядок Cantharellales Cantharellus cibarius
 Hydnum sp.
Hydnum sp.
 Агарикоидные гименомицеты
Агарикоидные гименомицеты
 Порядок Boletales Boletus edulis
Порядок Boletales Boletus edulis
 Leccinum scabrum
Leccinum scabrum
 Leccinum aurantiacum
Leccinum aurantiacum
 Suillus sp.
Suillus sp.
 Порядок Agaricales Agaricus sp.
Порядок Agaricales Agaricus sp.
 Pleurotus ostreatus
Pleurotus ostreatus
 Amanita muscaria
Amanita muscaria
 Armillaria mellea
Armillaria mellea
 Порядок Russulales Russula sp. Lactarius sp.
Порядок Russulales Russula sp. Lactarius sp.
 Группа порядков Гастеромицеты
Группа порядков Гастеромицеты
 Порядок Lycoperdales Lycoperdon perlatum
Порядок Lycoperdales Lycoperdon perlatum
 Порядок Sclerodermatales Scleroderma aurantium
Порядок Sclerodermatales Scleroderma aurantium
 Порядок Nidulariales Cyathus striatus
Порядок Nidulariales Cyathus striatus
 Порядок Phallales Phallus impudicus
Порядок Phallales Phallus impudicus
 Подкласс Heterobasidiomycetidae
Подкласс Heterobasidiomycetidae
 Порядок Dacryomycetales Calocera viscosa
Порядок Dacryomycetales Calocera viscosa
 Порядок Auriculariales Auricularia auricula
Порядок Auriculariales Auricularia auricula
 Порядок Tremellales Tremella sp. Exidia sp.
Порядок Tremellales Tremella sp. Exidia sp.
 Класс Ustilaginomycetes
Класс Ustilaginomycetes
 Порядок Ustilaginales
Порядок Ustilaginales
 Tilletia tritici
Tilletia tritici
 Ustilago tritici
Ustilago tritici
 Ustilago zeae (U. maydis)
Ustilago zeae (U. maydis)
 Порядок Exobasidiales Exobasidium vaccinii
Порядок Exobasidiales Exobasidium vaccinii
 Класс Urediniomycetes
Класс Urediniomycetes
 Порядок Uredinales
Порядок Uredinales
 Puccinia graminis
Puccinia graminis
 Отдел Deuteromycota Класс Hyphomycetes
Отдел Deuteromycota Класс Hyphomycetes
 Порядок Hyphomycetales
Порядок Hyphomycetales
 Aspergillus sp.
Aspergillus sp.
 Penicillium sp.
Penicillium sp.
 Trichoderma sp.
Trichoderma sp.
 Botrytis cinerea
Botrytis cinerea
 Ramularia tulasnei
Ramularia tulasnei
 Сercospora beticola
Сercospora beticola
 Fusicladium dendriticum
Fusicladium dendriticum
 Сylindrocarpon mali
Сylindrocarpon mali
 Fusarium graminearum
Fusarium graminearum
 Fusarium nivale
Fusarium nivale
 Monilia fructigena
Monilia fructigena
 Класс Coelomycetes
Класс Coelomycetes
 Порядок Melanconiales
Порядок Melanconiales
 Gloeosporium venetum
Gloeosporium venetum
 Cylindrosporium hiemale
Cylindrosporium hiemale
 Порядок Sphaeropsidales
Порядок Sphaeropsidales
 Ascoсhyta pisi
Ascoсhyta pisi
 Phyllosticta sp.
Phyllosticta sp.
 Septoria piricola
Septoria piricola


